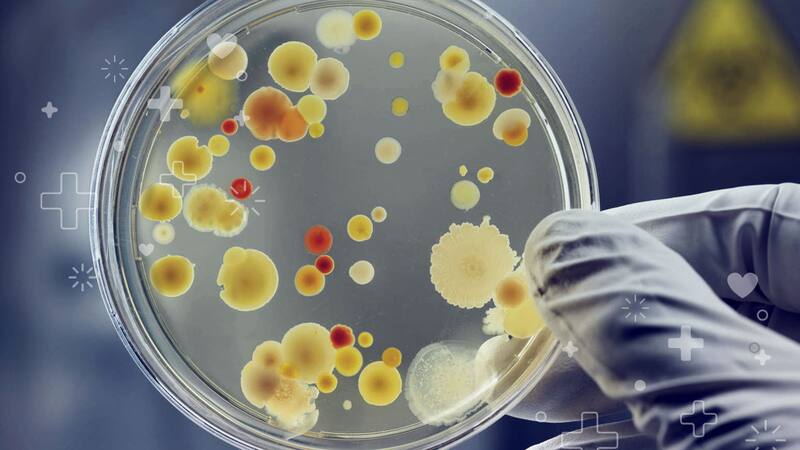

En esta noticia
La Agencia Nacional de Vigilancia Sanitaria (Anvisa) de Brasil confirmó el tercer caso positivo del hongo Candida auris, conocido popularmente como Super Hongo, y declaró el estado de "brote" local.
El paciente infectado se encuentra internado en el hospital público de Recife, del estado de Pernambuco (PE). La identificación fue hallada por el Laboratorio Central de Salud Pública Prof. Gonçalo Moniz - Lacen/BA.

Según señaló Anvisa, "se tomaron acciones para contener la propagación del organismo en el hospital y todavía hay otro caso sospechoso, que está bajo investigación".
"Aunque por el momento solo hay tres casos confirmados y otro en análisis en Brasil, se puede considerar que hay un brote de Candida auris en el país", apuntó la entidad.
La Agencia explicó además que la "definición epidemiológica" de un brote "abarca no solo una gran cantidad de casos de enfermedades contagiosas o relacionadas con la salud, sino también la aparición de un nuevo microorganismo en la epidemiología de un país o incluso de un servicio de salud, incluso si es solo un caso".
El superhongo, la amenaza global que puede ser la próxima pandemia
El Super Hongo es resistente a los medicamentos y la enfermedad causada por él puede desencadenar en la muerte del paciente. Se catalogó por primera vez cuando se encontró en el canal auditivo de un paciente en Corea del Sur en 2009. Desde entonces, se identificaron casos en más de 30 países como Estados Unidos, India, Inglaterra, Sudáfrica, Venezuela, Colombia, Israel, Pakistán, Kenia, Kuwait, Reino Unido y España, además de Brasil.

Según alertaron desde los Centros para el Control y la Prevención de Enfermedades de los de Estados Unidos (CDC, por sus siglas en inglés), "la amenaza para la salud mundial es tan grave que puede considerarse que el Super Hongo es la causa de la próxima pandemia".
Candida auris: ¿cómo es el SuperHongo y cómo se transmite?
El Candida auris es una especie de hongo que crece como levadura y puede permanecer en superficies inanimadas durante largos períodos, hasta meses.
Algunas investigaciones ya encontraron que varios desinfectantes, incluidos los basados en amonio cuaternario, no logran contrarrestar su presencia. Es por esta y otras razones que los científicos ya trataron al Super Hongo como el "patógeno casi perfecto".

El virus representa un mayor riesgo para los pacientes hospitalizados con sistemas inmunológicos comprometidos o hospitalizados en unidades de cuidados intensivos que hacen uso de catéteres y sondas vasculares.
En cuanto a su transmisión, no se conoce completamente, pero hay evidencia de que ocurre por contacto de persona a persona y también por contacto prolongado con superficies o dispositivos médicos contaminados por la cepa.













